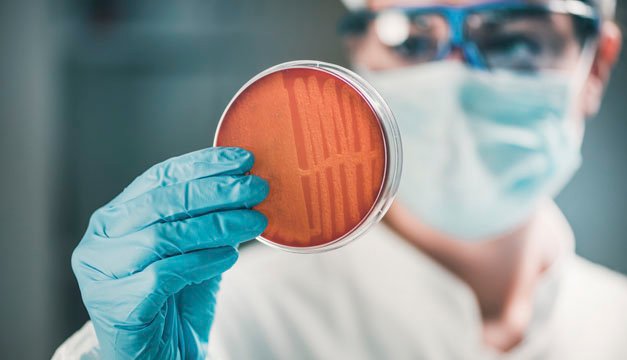

Durante muchos años alrededor del mundo se ha utilizado de manera incorrecta la ingesta de antibióticos, ante esto es importante aclarar que los antibióticos no curan virus como la gripe o resfriados, tampoco alivian el dolor ni la fiebre, sus componentes están diseñados para tratar infecciones provocadas por las bacterias.
Infecciones que en las últimas décadas se volvieron curables gracias a los antibióticos podrían empezar a matar nuevamente por el aumento de las bacterias resistentes a estos fármacos, advirtió la Organización Mundial de la Salud (OMS).
Una evaluación mundial -para la que 133 países han aportado datos- revela que esta problemática ya se ha convertido en una de las mayores amenazas para la salud global y que ignorarla sería "catastrófico".
La OMS confirma así que, sin medidas que lo eviten, el mundo se dirige a "una era postantibióticos", en la que "enfermedades comunes y heridas menores tratables por décadas pueden empezar nuevamente a matar", dijo en una rueda de prensa el experto de la OMS Charles Penn.
Las patologías comunes a las que se refería van desde la neumonía hasta el sida, pasando por la tuberculosis.
Cada año, por ejemplo, se registran cientos de miles de nuevos casos de tuberculosis multiresistente que es imposible de tratar.
Asimismo, existe el peligro de que se pierdan los beneficios de los avances médicos conseguidos mediante la quimioterapia o las cirugías mayores, agregó Penn.
El uso durante largo tiempo de los antibióticos y otros antimicrobianos genera naturalmente un proceso de resistencia, pero éste se acelera cuando se utilizan de forma excesiva, inapropiada o cuando son de mala calidad.
Uno de los principales problemas hallados es que la venta de antibióticos y otras medicinas antimicrobianas sin prescripción médica es habitual es muchos países, a lo que se suma la disponibilidad de medicamentos por internet.
Esto último provoca que las personas puedan tener acceso a medicamentos que no podrían comprar en una farmacia sin receta médica, incluso en países donde existe una buena regulación al respecto.
"La venta de antibióticos sin prescripción es muy común en todo el mundo, lo que hace que el potencial de mala utilización sea muy alto", explicó el especialista de la OMS.
Según la evaluación de la Organización -que declina apuntar a países específicos-, más de la mitad de los Estados de América aportaron datos indicando que la venta de medicinas antimicrobianas se hace sin receta médica.
"La gente tiene más conciencia que antes (de los riesgos del mal uso de los antibióticos), pero en general todavía es baja. Hay personas que siguen pensando que los antibióticos funcionan para infecciones virales, lo que hace que los usen cuando no es necesario", señaló Penn.
A esta situación contribuye que muchos países carezcan de directivas de tratamiento, lo que aumenta no sólo la automedicación, sino el mal uso o elección del antibiótico por parte de los médicos.
Otro factor que incrementa la incidencia de la resistencia es el que el tratamiento no sea completado.
El tercer problema encontrado son las medicinas de poca calidad y que no contienen la cantidad apropiada del ingrediente activo, lo que resulta en una dosificación menor a la que se cree.
Esta situación se agrava en el caso de los fármacos falsificados.
El informe presentado servirá de base de discusión al plan global de acción para combatir la resistencia a los antimicrobianos que los países miembros de la OMS abordarán en su asamblea anual de mayo en Ginebra.